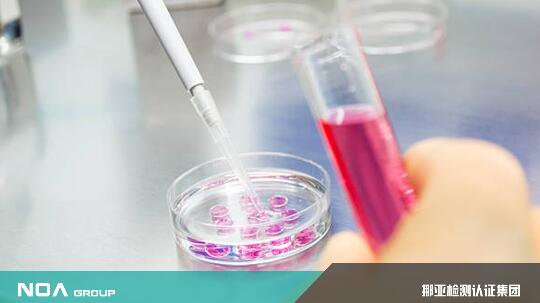

聚合物名词与特殊品直接联系,从科学角度可将聚合物理解为有很多结构单元且通过重复连接的高分子聚合物。在生活中,挪亚第三方检测机构可以承接高分子材料检测项目,在高分子材料渗透于人类各项生活中的背景下,材料革命正围绕着企业发生,而挪亚高分子聚合物成分分析技术已成为工业变革过程中的有迹可循。

高分子化合物是由千百个原子以共价键相互连接而成的,虽然它们的相对分子质量很大,但都是以简单的结构单元和重复的方式连接的。高分子化合物,简称高分子,又称高分子聚合物,挪亚检测研究表明一般指相对分子质量高达几千到几百万的化合物,绝大多数高分子化合物是许多相对分子质量不同的同系物的混合物,因此高分子化合物的相对分子质量是平均相对分子量。
在众多应用中,质谱技术由于其灵敏度高、分析速度快等特点被广泛的应用于化合物的表征。MALDI 技术作为一种“软电离”的离子化方式,使样品在离子化的过程中不会发生碎裂,因此,MALDI-TOF 可以直接测得聚合物的完整质量。而离子淌度质谱IM-MS作为一种新兴的质谱技术,由于其独特的分离原理,也被应用到复杂聚合物结构表征的领域当中来。
光散射强度与分子的大小及分子量有直接的关系,而SEC/GPC能分离不同尺寸及分子量的分子,结合此两种特性,挪亚第三方检测机构得到许多有用的信息,并广泛地应用于高分子,生化及动力学等研究领域。挪亚检测数据显示凝胶渗透色谱是快速鉴定聚合物高、低相对分子质量成分的重要的分析工具。
科技的发展逐渐使高分子聚合物成分分析技术走向成熟,运用在对多领域范围。挪亚检测在科技先行的检测背景下,拥有超高规模的实验室检测设备。挪亚检测可提供关于高分子材料、涂料、油品、金属等新材料发展产物相关的检测服务。挪亚检测为了使社会各界更加了解聚合物特征及成分分析技术,在官网配备专家进行在线解答等服务。

关注公众号
免费获取更多报告节选
免费咨询行业专家

2022-2027年有机高分子材料行业市场深度分析及发展规划咨询综合研究报告
中研普华通过对有机高分子材料行业长期跟踪监测,分析有机高分子材料行业需求、供给、经营特性、获取能力、产业链和价值链等多方面的内容,整合行业、市场、企业、用户等多层面数据和信息资源,...
查看详情
任何企业发展的成功离不开一位优秀的领导人,武汉真福医药股份公司也不例外。在多年的发展中,在公司董事长王业富先生...
过去两年,因为疫情而使经营业绩大受影响的行业,包括旅游、餐饮、影视、酒店等等,其中最有可能化危为机的,很可能是...
2019年之前,全国卡丁车运动市场不论是参与运动的人数或是运动场馆,一直以超过两位数的速度快速增长,调查统计,当前...
我国米酒历史悠久,因其酿制工艺简单,口味香甜醇美,含酒精量极低,因此深受人们的喜爱,目前已成为农家日常饮用的饮...
低度潮饮酒”指酒精度在0.5%-20%之间,在已有的酒精饮料基础之上,添加其他复合元素,突出综合口味,降低酒精味,在...
基于现有的视频编解码框架,编解码标准的更新和优化主要围绕各个技术子模块流程开展创新,编解码技术主要围绕:混合精...